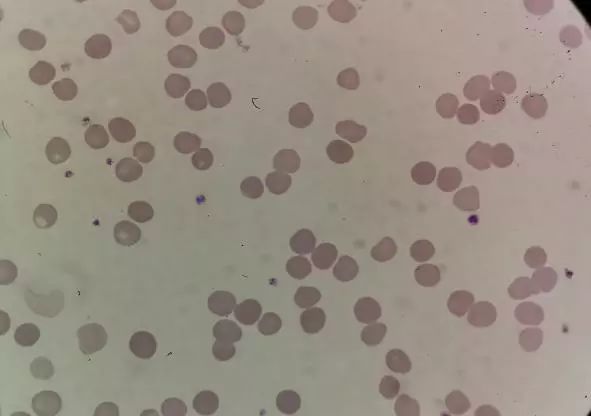

血小板计数究竟是多少?
作者:郝玉青
单位:联勤保障部队第980医院检验科
案例经过
患者,男,72岁,2019年10月21日中午因外伤来我院急诊就诊。
血常规初次检测PLT-I结果为1158,查看血小板直方图未见明显异常,给出”Thrombocytosis(血小板增多)”的提示,红细胞直方图可见红细胞波峰左侧出现一明显波峰,同时给出”Anisocytosis(红细胞大小不均)”及”Anemia(贫血)”的提示,如图1所示:

▲图1
操作人员注意到血小板结果较异常增高,复测后依旧。于是加做PLT-F为136,血小板直方图无明显异常。如图2所示:

▲图2
前后结果相差近10倍。结合红细胞直方图可见红细胞波峰左侧出现一明显波峰,考虑是否有小红细胞的干扰,但MCV为106.6fL,也不支持小红细胞,白细胞散点图也没提示有很多细胞碎片。
查看病人还做了凝血检查除D-二聚体稍高外其余指标均正常。是什么原因使血小板假性增高呢?于是涂片镜检,镜下形态如图3、图4:
▲图3

▲图4
涂片中血小板及白细胞形态大致正常,薄片处未见细胞碎片、小红细胞、细菌及真菌等。估算血小板数量与PLT-F值相近,但背景可见不定形物及红细胞呈不规则形。该患者为急诊,先按PLT-F报告结果。
后与急诊接诊医生联系,得知该患者曾在院外曾诊断为冷球蛋白血症,现外伤处理好后离院了。
难道镜下的不定形物是冷球蛋白?查找并参考文献,该病人很有可能为少见的冷球蛋白干扰PLT-I计数的情况。
案例分析
该患者血常规及凝血标本在室温放置3小时后,标本呈现凝固、半凝固状态。如图5、6:

▲图5

▲图6
使用37℃水浴温浴30min的方法,检测结果如图7所示:

▲图7
PLT-I被纠正到165,同时PLT直方图无异常提示,RBC直方图红细胞波峰左侧波峰消失。与此同时用温浴的血涂片镜检,镜下形态如图8、图9:

▲图8

▲图9
涂片背景干净很多,不定形物基本消失,红细胞形态大致正常。可见温浴效果明显。又用凝血的血浆加做了免疫球蛋白,IgA、IgG正常,IgM为5.04 g/L。
那该患者极有可能是冷球蛋白IgM导致的血细胞分析仪测定血小板假性增多。
总  结
血细胞分析仪电阻抗法适用于常规标本的筛检,对于大血小板及微小血小板有漏检的情况,而细胞碎片、小红细胞、细菌等干扰会导致计数不准确。
患者血常规标本中形成的冷沉淀颗粒可能被血细胞分析仪归为血小板,使得在计数上,PLT-I的计数往往是PLT真实值的几倍甚至数十倍。
而PLT直方图无法直观地反应出该干扰因素的存在,甚至不会引起仪器报警,极容易造成漏诊及误诊。
PLT-F的检测原理是荧光染色。荧光染料以噁嗪为主,可以有效去除细胞碎片、小红细胞的干扰,与流式细胞分析法原理类似,由于非血小板颗粒不会被荧光染料染色,所以抗干扰能力强,由于其分析量的增加且在低值血小板有更好的准确性和重复性。
由于冷球蛋白血症常继发于多种原发疾病当中,除原发病的临床表现外,部分病例可没有症状。临床医生也应该对冷球蛋白血症引起重视,当怀疑可能存在冷球蛋白血症症状的患者,也应该与检验科室沟通,关注血小板计数,从而避免漏误诊。
另外检验人员应提高技能,及早发现问题,解决问题,为临床提供一份可靠的报告!

